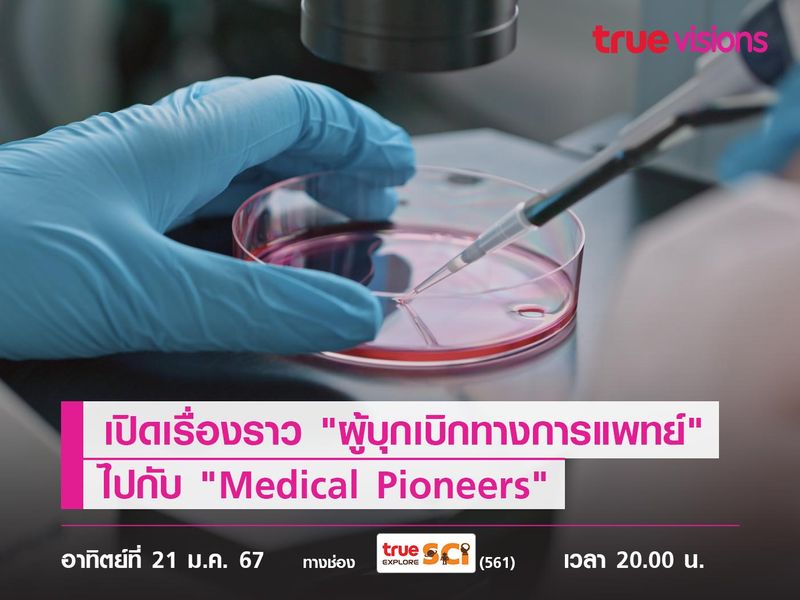
เปิดตำนาน "ผู้บุกเบิกทางการแพทย์" ไปกับ "Medical Pioneers"

สารคดี "Medical Pioneers" จะนำเสนอเรื่องราวของนักวิจัยและนักประดิษฐ์จากทั่วโลก กับการคิดค้นอนาคตและโครงการลับของพวกเขาที่พร้อมจะเปลี่ยนแปลงโลกของพวกเราให้ดียิ่งขึ้น
ยังคงเป็นอีกหนึ่งวิชาการที่หลายคนต้องยกย่องสำหรับ "เทคนิคทางการแพทย์" ที่ช่วยรักษาให้ผู้คนนับล้านหายจากโรคร้ายต่างๆ ที่นับวันก็จะยิ่งเพิ่มความรุนแรงมากขึ้นตามการเปลี่ยนแปลงของโลก โดยสารคดี "Medical Pioneers" จะนำเสนอเรื่องราวของนักวิจัยและนักประดิษฐ์จากทั่วโลก กับการคิดค้นอนาคตและโครงการลับของพวกเขาที่พร้อมจะเปลี่ยนแปลงโลกของพวกเราให้ดียิ่งขึ้น ซึ่งการที่พวกเขาเหล่านั้นได้บุกเบิกเรื่องราวของการแพทย์เพื่อรักษาคนทั้งโลกนั้นส่งผลดีโดยตรงกับคนอย่างแน่นอน ยิ่งไปกว่านั้นยังได้เห็นถึงเบื้องลึก เบื้องหลังของกว่าจะมาเป็นเรื่องราวสิ่งประดิษฐ์ต่างๆ นั้นก็ต้องผ่านกระบวนการคิดที่ไม่ธรรมดาเช่นเดียวกัน โดยผู้คิดริเริ่มเองจะต้องมีการคิดนอกกรอบ พร้อมทั้งยังมีความรู้ที่ตนเองมีอยู่นั้น สร้างให้เกิดเป็นชิ้นงานใหม่ๆ ที่ไม่ธรรมดาได้


รับประกันว่าหากคุณเป็นหนึ่งคนที่ชื่นชอบในเรื่องราวของการแพทย์ หรือจะเป็นชอบดูแลตัวเอง หริออยากรู้เรื่องราวลึกๆ ของการแพทย์จะต้องไม่พลาดสำหรับสารคดีชุดนี้ แถมยังได้เหมือนนั่งย้อนเวลากลับไปเพื่อค้นพบสิ่งใหม่ๆ ในยุคนั้นรับรองว่าได้ทั้งความรู้ แถมยังได้เห็นมุมมองความคิดของคนในอดีตต่อการแพทย์อีกด้วย ถึงตอนนี้คงอยากที่จะติดตามกันแล้ว สามารถรับชมได้วันนี้เวลา 20.00 น. ทางช่อง True Explore SCI 561 #TrueVisions #สารคดี #TrueExploresci #การแพทย์ #เทคนิคทางการแพทย์ #MedicalPioneers

truevisions
อัปเดตข่าวล่าสุดก่อนใคร :
Website : www.truevisions.co.th
Facebook : Truevisions
Twitter : @TrueVisions
Line : @Truevisions
Youtube official : Truevisionsofficial
Instagram : Truevisionsofficial




















